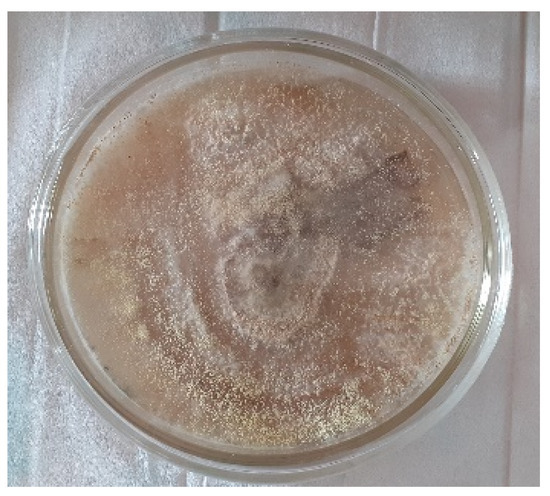

Abstract
Aspergillus sp. is a microscopic fungus that can properly degrade Industrial effluents such as batik dye effluents. The innovation of making liquid organic fertilizer (LOF) from degraded batik dye and tofu effluents can be a sustainable solution to overcoming environmental problems and advancing the agricultural sector, especially with regard to the use of organic fertilizer for agricultural crop productivity. Organic substances found in tofu effluents and degraded batik dye effluents have the potential to support organic fertilizer elements. The results of this study showed that the addition of LOF from degraded batik dye and tofu effluents on mung bean plants (Vigna radiata) affected the best growth response on plant height, wet weight, root length, and seed viability rate.
1. Introduction
One Industrial Effluents, Synthetic batik dye effluents have a high level of toxicity [1] and can disturb the photosynthetic processes of plants [2]. Aspergillus sp. is a fungi species used to degrade batik dye effluents [3,4]. One example, Aspergillus sp. 3, can decrease the levels of total dissolved solids (TDS), electrical conductance (EC), biological oxygen demand (BOD), total suspended solids (TSS), chemical oxygen demand (COD), temperature, and pH of the batik effluents. Moreover, it could also decrease the concentration of oil or fat in batik dye effluents [5]. The potential test result of degraded batik dye effluents by Aspergillus sp. 3 does not give a toxic effect on the growth of corn and green bean crops [3]. Previous research has shown that the length of roots and stems of Zea mays and Vigna radiata watered by degraded batik dye effluents are longer than those watered by water (control) [3,4,5]. This research showed that degraded batik dye effluents have the potential as a liquid organic fertilizer (LOF). Here, we found that the degraded result became simple compounds that could be used as macronutrient sources for plants; therefore, we determined that it would not cause any environmental harm when disposed of.
The other industry such as tofu has significantly developed In Indonesia, resulting in tofu effluents [6]. Previous analyses have examined how tofu effluents contained carbohydrates, proteins, fats, N, P, K, Ca, Mg, and Fe. The substances on tofu effluents have the potential to become a LOF [7]. Tofu effluents are the effluents that emerge from the tofu production process in the form of wastewater and contain nutrients N 1.24%, P2O5 5.54%, K2O 1.34%, and C-Organic 5.8%, all of which are essential nutrients for plants [8]. Tofu effluents can be processed into LOF with the help of effective microorganism-4 (EM4) [9]. Nutrients in tofu effluents have the potential to become a LOF.
Organic farming has become a cause for concern in some countries, especially in Indonesia. Organic farming requires the use of organic fertilizer as an alternative nutrient solution [10]. The basic materials of organic fertilizer come from dead living things, such as animal waste, plant waste, or household waste that experienced the process of decay by decomposing organisms [11]. LOF comes from plants and animals that fermented and produced the liquid. LOF contains nutrients such as Phosphor, Nitrogen, and Potassium, all of which are important for plants to repair soil nutrients [12]. The application of LOF to hydroponics systems is more efficient than the soil medium system [9,13].
The AB mix is one of the LOF that is most popular in the hydroponic system due to a large amount of macronutrients it provides for plants, such as NH4 (14 ppm), NO3 (150.5 ppm), H2PO4 (38.75 ppm), and K (253.5 ppm), all of which are very good for plant growth in hydroponic systems [14]. Thus, the parameters of plant height, wet weight, and dry weight had a strong effect on lettuce plants compared to only the addition of LOF treatment of tofu effluents [15]. Therefore, in this research, we sought to obtain another macronutrient source instead of the AB mix to create a new LOF to be used as a source of macronutrients from degraded batik dye and tofu effluents.
This research aimed to determine the ability of LOF from degraded batik dye and tofu effluents to enhance the growth of mung beans. Further, we aspired to determine the best effect of its LOF to enhance the growth of mung beans based on the given LOF concentration.
2. Materials and Methods
2.1. Media and Effluents
The media used in this research was potato dextrose agar (PDA). It contained 20 g of dextrose, 20 g of agar, 200 g of potato, and aquades of 1000 mL. Potato dextrose broth (PDB) contained 20 g of dextrose, 200 g of potato, and aquades of 1000 mL. Batik dye effluents were taken from Sokaraja, Banyumas Regency, Central Java, Indonesia. Tofu effluents were taken from the Tofu Factory Kaliputih in Purwokerto, Banyumas Regency, Central Java, Indonesia.
2.2. Isolate
Aspergillus sp. 3 has been previously identified as the G.Pn strain of Aspergillus sclerotiorum [16]. The morphological character of this species has a golden yellow colony with a 45-mm diameter colony constructed by the vesicle, metulae, and philiades. The foot cell has a spore diameter in the range of 2.5–3.0 μm [3,16].
2.3. Re-Culture of Aspergillus sp. 3
We re-cultured the fungi Aspergillus sp. on the PDA medium for 7 days at 28 °C. After that, we used 5 plugs of Aspergillus sp. 3 to re-culture on the PDB medium for 5 days at 28 °C. We then put it on a shaking incubator at 70 rpm.
2.4. Degradation Process
The degradation process was commenced by adding 100 mL of batik dye effluents into the PDB medium containing Aspergillus sp. 3. The degradation process was complete after 4 h in the shaking incubator at 70 rpm. The color changed from dark blue into a clear yellow. The result of the degradation was obtained via filtration.
2.5. Making LOF
The LOF comprised of degraded batik and tofu effluents, in a ratio of 1:1, were homogenized and mixed with 10% EM4 and brown sugar. Fermentation was anaerobically carried out for 7 days. The LOF was used after the fermentation process.
2.6. LOF Application in a Wick Hydroponic System
The LOF was applied to mung bean seeds via a hydroponic wick system (Figure 1). Our research method was a completely randomized design (CRD) with the treatment of LOF concentration. Each treatment had 3 replications. The treatments used in the test were as follows: T0: water without LOF; T1: AB mix (10 mL/1000 mL water); T2: LOF (20 mL/1000 mL water); T3: LOF (30 mL/1000 mL water); T4: LOF (40 mL/1000 mL water); and T5: LOF (50 mL/1000 mL water). The tests were carried out for 7 days and data were taken in the form of height, wet weight, root length, and seed viability rate.

Figure 1.
Hydroponic wick system.
3. Result and Discussion
The fungi species used for the decolorization and degradation of the batik effluent was Aspergillus sp. 3 (Figure 2). The species was identified and paten as Aspergillus sclerotiorum G.Pn strain [16]. This species was found to be the superior microfungi in terms of its ability to decolorize the batik effluent. This species was able to reduce the color of batik effluents by 98.26% with the largest weight of a mycelial. The Aspergillus sclerotiorum G.Pn strain showed the highest efficiency for degrading the effluent containing Indigosol Blue-04B and was more efficiently used for mycoremediation [3,16].
Figure 2.
Aspergillus sp. 3.
Aspergillus sp. 3 was found to have the ability to degrade the batik dye effluents. This was proven by the noted change of color (Figure 3a,b). The color change was a result of decreased toxicity levels, which were indicated by the value according to the waste quality standard. The degradation of batik effluents from Aspergillus sp. 3 reduced Cr concentration from 1.1 mg/L to be <0.12 mg/L, sulfide concentration from 2.95 mg/L to 0.5 mg/L, ammonia concentration from 127.2 mg/L to 55.5 mg/L, phenol concentration from 0.33 mg/L to 0.17 mg/L, and oil-fat from 10.992.75 mg/L to 539.75 mg/L [5]. Decreased toxicity due to the Aspergillus sp. degradation process was used as a reference for in vitro tests on plants such as corn and mung beans.

Figure 3.
(a) Batik dye effluents; (b) degraded batik dye effluents; (c) LOF.
Table 1 and Figure 4 show the growth of mung beans in a hydroponic system based on the application of LOF (Figure 3c) from degraded batik dye and tofu effluents. The data on plant height reported in Figure 4 shows that there were no far distances in plant height on day 1 after planting. However, on day 7 after planting, the maximum plant height was found in the LOF treatment, with a level of 20 mL of 19.83 ± 0.09 cm. The shortest height was 14.21 ± 2.79 cm. The LOF treatment of 20 mL had the best effect on plant height compared to other treatments, such as water and the AB mix. Other research showed that the stem length of Z. mays and V. radiata when treated by degraded batik dye effluents, grew higher than when watered by water (control) [3,4,5]. Similarly, additional research showed that a high (100%) concentration of LOF tofu effluent had the best effect on the height of chili plants (Capsicum annum L.) rather than those treated by a low concentration of LOF tofu effluents [17].

Table 1.
Plant height day 7 after planting, root length, wet weight, and seed viability rate at 7 days after planting.

Figure 4.
Graph of plant height at 1 day and 7 days after planting.
Adding the LOF to the wet weight showed that the maximum plant weight was found in two LOF treatments. The first had levels of 20 mL and 50 mL with weights of 0.37 ± 0.04 g and 0.37 ± 0.05 g. The lowest wet weights recorded had levels of 30 mL and 40 mL and weights of 0.28 ± 0.09 g and 0.28 ± 0.08 g. These findings concurred with previous research that reported that adding tofu west to LOR positively impacted the growth parameters (e.g., plant height, number of leaves, stem diameter) of mung beans [18].
Applying the LOF positively impacted mung beans’ root length. When the LOF had a level of 20 mL, the root length was at its highest (i.e., 11.1 ± 2.32 cm). The shortest length of the root occurred during the AB mix treatment when the length was 3.09 ± 0.41 cm. Previous research showed that the LOF treated with 60% tofu compared to red spinach (Alternanthera amoena Voss) without fertilizer had a strong root growth due to the potassium in the LOF. As such, it is clear that tofu effluents increases root elongation and improves drought tolerance [19].
Table 1 shows that the viability rate of mung bean seeds after being treated with water, the AB mix, 20 mL of LOF, and 50 mL of LOF is 100%. The viability rate of mung bean seeds after being treated with 30 mL of and 40 mL of LOF was 67–100%. Previous research showed that Aspergillus sp. 3 isolates were able to decolorize effluents up to 99.9% and decrease the toxicity level of batik dye effluents [3]. The degradation treatment of batik dye effluents on corn and mung bean seeds were shown to impact growth positively, especially when compared to other treatment of batik dye effluents [3,4].
The effect of LOF on plants can be seen clearly in the appearance of overall growth, i.e., plant height and root length (Figure 5). Figure 5 shows that the presence of mixed LOF fermentation from degraded batik dye and tofu effluents was better than the use of water and as good as the use of the AB mix in the hydroponic system on mung bean plants.

Figure 5.
Plants after 7 days treated by LOF levels. (a) Plants treated by water or control; (b) plants treated by AB mix (T1); (c) plants treated by LOF 20 mL (T2); (d) plants treated by 30 mL of LOF (T3); (e) plants treated by LOF 40 mL (T4), (f) plants treated by 50 mL of LOF (T5).
4. Conclusions
The research revealed that the addition of LOF from industrial effluent (degraded batik and tofu effluents) affected plant height, wet weight, root length, and seed viability. The addition of 20 mL of LOF showed the best responses on plant height, root length, wet weight, and seed viability (19.83 ± 0.09 cm, 11.1 ± 2.32 cm, 0.37 ± 0.04 g, and 100%, respectively).
Author Contributions
Conceptualization, R.S.D. and N.H.G.; methodology, R.S.D., N.H.G., M.A. and L.B.; software, L.B.; validation, R.S.D.; formal analysis, R.S.D.; investigation, N.H.G. and M.A.; resources, R.S.D., N.H.G. and M.A.; data curation, L.B.; writing—original draft preparation, N.H.G.; writing—review and editing, R.S.D. and L.B.; visualization, M.A.; supervision, R.S.D.; project administration, R.S.D. and N.H.G.; funding acquisition, R.S.D., N.H.G., M.A. and L.B. All authors have read and agreed to the published version of the manuscript.
Funding
This research received funding from the Institute for Research and Community Service (LPPM) Universitas Jenderal Soedirman under the “Applied Research” Scheme in 2021.
Institutional Review Board Statement
Not applicable.
Informed Consent Statement
Not applicable.
Data Availability Statement
Not applicable.
Acknowledgments
The authors would like to thank Institute for Research and Community Service (LPPM) Universitas Jenderal Soedirman which has funded this research.
Conflicts of Interest
The authors declare no conflict of interest.
References
- Yulita, A.; Lestari, S.; Dewi, R.S. Dekolorisasi Limbah Cair Batik Menggunakan Miselium Jamur yang Diisolasi dari Limbah Baglog Pleurotus ostreatus. Maj. Ilm. Biol. Biosf. A Sci. J. 2013, 30, 90–95. [Google Scholar]
- Dewi, R.S.; Khotimah, K. Aspergillus sp. 3 Pada Pengolahan Limbah Cair Batik Kutawaru Cilacap dan Pengaruhnya terhadap Zea mays dan Vigna radiata. Life Sci. 2019, 8, 150–159. [Google Scholar]
- Dewi, R.S.; Kasiamdari, R.S.; Martani, E.; Purwestri, Y.A. Decolorization, and detoxification of batik dye effluent containing Indigosol Blue-04B using fungi isolated from contaminated dye effluent. Indones. J. Biotechnol. 2018, 23, 54–60. [Google Scholar] [CrossRef] [Green Version]
- Dewi, R.S.; Kasiamdari, R.S.; Martani, E.; Purwestri, Y.A. Bioremediation of Indigosol Blue 04B Batik effluent by Indigenous Fungal Isolates, Aspergillus spp. Omni-Akuatika 2018, 14, 11–20. [Google Scholar] [CrossRef]
- Dewi, R.S.; Kasiamdari, R.S.; Martani, E.; Purwestri, Y.A. August. Efficiency of Aspergillus sp. 3 to reduce chromium, sulfide, ammonia, phenol, and fat from batik wastewater. IOP Publishing, Volume 308, 2019; 012003. In Proceedings of the IOP Conference Series: Earth and Environmental Science, International Symposium on Bioremediation, Biomaterial, Revegetation, and Conservation, Bogor, West Java, Indonesia, 27–28 September 2018. [Google Scholar]
- Aliyenah, A.; Napoleon, A.N.A.; Yudono, B. Pemanfaatan Limbah Cair Industri Tahu Sebagai Pupuk Cair Organik Terhadap Pertumbuhan dan Produksi Tanaman Kangkung Darat (Ipomoea reptans Poir). J. Penelit. Sains 2015, 17, 1–9. [Google Scholar]
- Wati, I. Pengaruh Pemberian Limbah Cair Tahu Terhadap Pertumbuhan Vegetatif Cabai Merah (Capsicum Annum L.) Secara Hidroponik Dengan Metode Kultur Serabut Kelapa. Ph.D. Thesis, Universitas Muhammadiyah Malang, Fakultas Keguruan dan Ilmu Pendidikan, Malang, Indonesia, 2008. [Google Scholar]
- Rasmito, A.; Hutomo, A.; Hartono, A.P. Pembuatan Pupuk Organik Cair dengan Cara Fermentasi Limbah Cair Tahu, Starter Filtrat Kulit Pisang Dan Kubis, dan Bioaktivator EM4. J. IPTEK 2019, 23, 55–62. [Google Scholar] [CrossRef] [Green Version]
- Samsudin, W.; Selomo, M.; Natsir, M.F. Pengolahan limbah cair industri tahu menjadi pupuk organik cair dengan penambahan effektive mikroorganisme-4 (EM-4). J. Nas. Ilmu Kesehat. 2018, 1, 1–14. [Google Scholar]
- Abror, M.; Harjo, R.P. Efektifitas Pupuk Organik Cair Limbah Ikan dan Trichoderma sp. Terhadap Pertumbuhan dan Hasil Tanaman Kailan (Brassica oleracea sp.) Pada Sistem Hidroponik Substrat. J. Agrosains Dan Teknol. 2018, 3, 1–12. [Google Scholar] [CrossRef]
- Al-Amin, A.; Yulia, A.E.; Nurbaiti, N. Pemanfaatan Limbah Cair Tahu untuk Pertumbuhan dan Produksi Tanaman Pakcoy (Brassica rapa L.). JOM Faperta. 2017, 4, 1–11. [Google Scholar]
- Kurniawan, E.; Ginting, Z.; Nurjannah, P. Pemanfaatan Urine Kambing pada Pembuatan Pupuk Organik Cair Terhadap Kualitas Unsur Hara Makro (NPK). In Proceedings of the Seminar Nasional Sains dan Teknologi, Jakarta, Indonesia, 1–2 November 2017; pp. 1–10. [Google Scholar]
- Wahyuningsih, A.; Fajriani, S. Komposisi Nutrisi dan Media Tanam Terhadap Pertumbuhan dan Hasil Tanaman Packcoy (Brassica rapa L.) Sistem Hidroponik. J. Prod. Tanam. 2016, 4, 595–601. [Google Scholar]
- Wijayanti, E.; Anas, D.S. Pertumbuhan dan Produksi Dua Varietas Tomat (Lycopersicon esculentum Mill.) Varieties Hydroponically with some Growing Media Composition. Bul. Agrohorti 2013, 1, 104–112. [Google Scholar] [CrossRef]
- Charolina, A.; Setyaningsih, M.; Faruq, H. The Utilization of Tofu Waste Water as An Addition of Nutrition in Hydroponic Media to Lettuce Growth (Lactuca sativa L.). IOP Publishing: 2021; Volume 755, p. 012049. In Proceedings of the IOP Conference Series: Earth and Environmental Science, Jakarta, Indonesia, 25 November 2020. [Google Scholar]
- Dewi, R.S. Aspergillus sclerotiorum Strain G.NP: Fungi Unggul Dalam Dekolorisasi Limbah Batik. Patent Indonesia Granted No. IDS000003578, 26 January 2021. [Google Scholar]
- Pratiwi, H.; Darmawati, A.; Budiyanto, S. Pengaruh Konsentrasi dan Frekuensi Pemberian POC Limbah Tahu terhadap Pertumbuhan dan Produksi Cabai Merah (Capsicum annum L.). Buana Sains 2021, 21, 87–98. [Google Scholar]
- Junaedi, M.N.M.; Saleh, I.; Wahyuni, S. Respon Pertumbuhan Kacang Hijau (Vigna radiata L.) pada Beberapa Konsentrasi dan Frekuensi Pemberian Limbah Cair Tahu Sebagai Pupuk Organik Cair. J. AgroSainTa: Widyaiswara Mandiri Membangun Bangsa 2021, 5, 41–48. [Google Scholar] [CrossRef]
- Anggraini, W.; Zulfa, M.; Prihantini, N.N.; Batubara, F.; Indriyani, R. Utilization of Tofu Wastewater for The Growth of Red Spinach (Alternanteraamoenavoss) in Floating Raft Hydroponic Cultures. In Journal of Physics: Conference Series; IOP Publishing: Bristol, UK, February 2020; Volume 1467, p. 012005. [Google Scholar]
Publisher’s Note: MDPI stays neutral with regard to jurisdictional claims in published maps and institutional affiliations. |
© 2022 by the authors. Licensee MDPI, Basel, Switzerland. This article is an open access article distributed under the terms and conditions of the Creative Commons Attribution (CC BY) license (https://creativecommons.org/licenses/by/4.0/).





